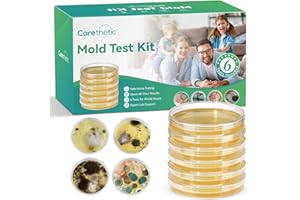
Carethetic Mold Test Kit for Home - 6 DIY Tests Included for Air, Surface & HVAC, Lab Analysis & Expert Consultation

ÂéķđĮø ÂéķđĮø
Our most popular products based on sales. Updated frequently.
- âđAny Department
- âđIndustrial & Scientific
- âđTest, Measure & Inspect
- Airflow & Air Quality
- Anemometers
- Barometers
- Indoor Air Quality Meters(Current)
- Manometers
ÂéķđĮø in Indoor Air Quality Meters
 |
Your recently viewed items and featured recommendations
After viewing product detail pages, look here to find an easy way to navigate back to pages that interest you.
Get to Know Us
Make Money with Us
ÂéķđĮø Payment Products
ÂĐ 1996-2026, ÂéķđĮø. or its affiliates
- ÂéķđĮø.com.ca ULC | 40 King Street W 47th Floor, Toronto, Ontario, Canada, M5H 3Y2 |1-877-586-3230